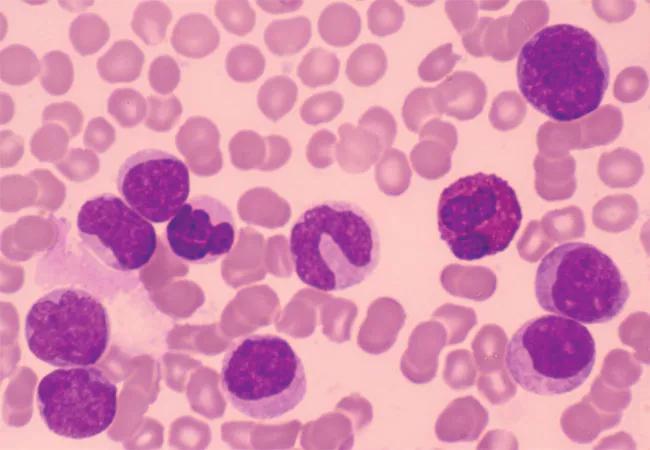

Single-cell next-gen sequencing showing promise to improve sensitivity of MRD testing
Image content: This image is available to view online.
View image online (https://assets.clevelandclinic.org/transform/cc5027ee-576c-498a-b8d1-1c15c0181f8f/23-CNR-3965756-CQD-Hero-650x450-Dr-Molina_jpg)
23-CNR-3965756-CQD-Hero-650×450 Dr Molina
Assessment of measurable residual disease (MRD) is recommended for routine follow-up of patients who have undergone allogeneic hematopoietic stem cell transplant (HSCT) as treatment for leukemias. Cleveland Clinic researchers are exploring single-cell next-generation sequencing (NGS) in an effort to overcome limitations with existing methodologies to monitor MRD in acute myeloid leukemia (AML) and myelodysplastic syndromes. They highlight the latest advances in MRD detection in a paper in Cancers.
Advertisement
Cleveland Clinic is a non-profit academic medical center. Advertising on our site helps support our mission. We do not endorse non-Cleveland Clinic products or services. Policy
Measurable residual disease refers to persistence of leukemic cells in the bone marrow or peripheral blood of patients in morphologic complete remission after treatment. In the context of transplantation, MRD testing can be performed prior to HSCT to establish the baseline disease level for improved risk stratification, as the presence of MRD correlates with worse survival and a higher risk of relapse. Pre-transplantation, MRD status can also guide therapeutic interventions, such as the intensity of pre-transplant conditioning or post-transplant chemotherapy. Post-transplantation, MRD monitoring can provide objective evidence of treatment response.
Current assays for MRD detection rely on either immunophenotyping via multiparametric flow cytometry (MFC) or molecular testing. Multiparametric flow cytometry has a sensitivity of about 10-4, (capable of detecting one abnormal cell in 10,000 cells). “We’re limited by our best tests. We don’t know if there’s a lower level of disease that we can’t yet detect, and whether we can detect disease at a lower level with more sensitive techniques,” says John C. Molina, MD, Associate Staff Physician, Division of Leukemia & Myeloid Disorders at Cleveland Clinic, and a co-author on the paper.
Molecular testing is used to detect leukemia-defining mutations but a specific assay is required for every mutation. Bulk NGS of MRD has the ability to evaluate simultaneously multiple regions often mutated in AML, allowing for better inference of clonal and subclonal MRD burden. Serial bulk NGS measurements can monitor changing mutational dynamics clones with treatment.
Advertisement
One concern with molecular testing to monitor MRD is detection of specific preleukemic clones and labeling them as persistent disease, with the risk of modifying therapy inappropriately based on this assessment.
“A mutation detected by current assays may be part of the leukemia or it may be a mutation that led to the leukemia and is no longer an actual leukemic cell,” says Dr. Molina. “Also, certain mutations detected with current assays may not be indicative of residual disease that affects outcomes [truly positive], which can influence the decision to take patients to transplant. It’s a challenge to know that what we’re detecting is persistence of disease.”
He continues, “We don’t know with certainty what level of MRD positivity is clinically significant. Does every patient have to have undetectable MRD, or are there certain levels of MRD for which transplant outcomes won’t be negatively affected?”
Single-cell NGS sequencing methods allow for tagging molecular AML fragments specific to individual cells, and is becoming the standard for probing intratumoral heterogeneity. However, single-cell sequencing is time-consuming, and single-cell DNA sequencing requires whole-genome amplification from a low DNA amount.
Presently, single-cell NGS is at the level of research and investigation. The clinical utility of single-cell sequencing in monitoring MRD has shown promising results in AML/MDS. “The technology is wonderful, and I think we’ll get there, but we have to scale up the technology,” he says. “Many of the limitations of single-cell NGS at this point are cost-associated. It is currently limited to research and clinical trials. The next step is to broaden the application of this technology to be able to use it efficiently.”
Advertisement
Cleveland Clinic will be participating in the national Molecular Evaluation of AML Patients After Stem Cell Transplant to Understand Relapse Events (MEASURE), which is a prospective determination of the clinical utility of MRD testing for relapse and survival of patients with AML undergoing allogeneic hematopoietic cell transplantation.
The goal is to obtain a better understanding of factors that lead to relapse after treatment, and the performance of technologies such as single-cell RNA and DNA sequencing, using data from a large population of AML patients. “We would like to gain the information to then incorporate these technologies in the future, in terms of treatment protocols and effective MRD monitoring,” says Dr. Molina.
Subjects will be asked to provide blood samples at intervals up to 18 post-transplant. Additional blood and marrow samples will be requested at relapse if it occurs.
Advertisement
Advertisement
First-of-its-kind research investigates the viability of standard screening to reduce the burden of late-stage cancer diagnoses
Global R&D efforts expanding first-line and relapse therapy options for patients
Study demonstrates ability to reduce patients’ reliance on phlebotomies to stabilize hematocrit levels
A case study on the value of access to novel therapies through clinical trials
Findings highlight an association between obesity and an increased incidence of moderate-severe disease
Cleveland Clinic Cancer Institute takes multi-faceted approach to increasing clinical trial access 23456
Key learnings from DESTINY trials
Overall survival in patients treated since 2008 is nearly 20% higher than in earlier patients